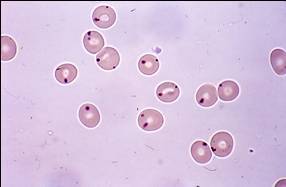

How to calculate drug clearance
clearance = rate of drug elimination/plasma drug concentration
Common pulmonary infection in HIV patient
Fxn + name of HIV surface proteins
Stage of cell cycle of oocyte from birth to ovulation
prophase I
Oocyte cell cycle from ovulation ==> embryo
Lead impact on heme synthesis
Tx w/penicillins, sulfonamides followed by fatigue, temp + erythematous macules/papules + burning sensation ==> Dx?
Drugs that ==> Stevens-Johnson syndrome
Dx?

Tx of Pneumocystitis jiroveci pneumonia (+ MOA)
Characteristics of H. pylori
p53 gene fxn
location of p53 gene
chromosome 17
Consequences of loss of p53 gene
diagnostic criteria for Li-Fraumeni syndrome
Celiac artery supplies blood to ….?
fever + runny nose + bilateral cervical lymph nodes ==> Dx?

Corynebacterium diptheria infection
MOA of diptheria toxin
Consequence of 21-alpha-hydroxylase deficiency
unable to synthesize mineralocorticoids ==> chronically elevated renin levels
Pathophysiology of osteogenesis imperfect
Mutations in Type 1 osteogenesis imperfecta
Pathologic finding?
Presentation of G6PD